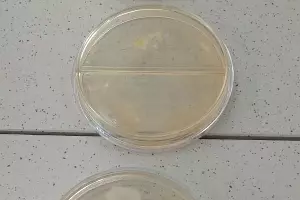
&copy;&nbsp;Фото Елены Малышевой, Юга.ру

Группа школьников из Адыгеи разрабатывает состав медицинской пленки, которая будет задерживать распространение микробов
Группа школьников работает под руководством преподавателей Майкопского государственного технологического университета (МГТУ), рассказала порталу Юга.ру участница зимней проектной школы лаборатории «Полярис — Адыгея» по направлению «биотехнологии» Мария Мариенко.
По ее словам, ученые вуза, в состав которого входит медицинский институт, уже более 20 лет работают над изобретением медицинской пленки. За это время удалось создать уникальную пленку и получить на открытие патент.
«Изобретение имеет практическое назначение. Пленка уже успешно используется в области кардиологии врачами Адыгейской республиканской больницы. На этом ученые не останавливаются и вместе с одаренными школьниками изобретают новый состав пленки для других областей медицины», — добавила Мариенко.
Кроме того, новую пленку, которая останавливает распространение микробов, можно использовать для заживления ран.
«Уже есть первые результаты. Опыты показали: где есть пленка, останавливается рост микробов», — заключила Мариенко.